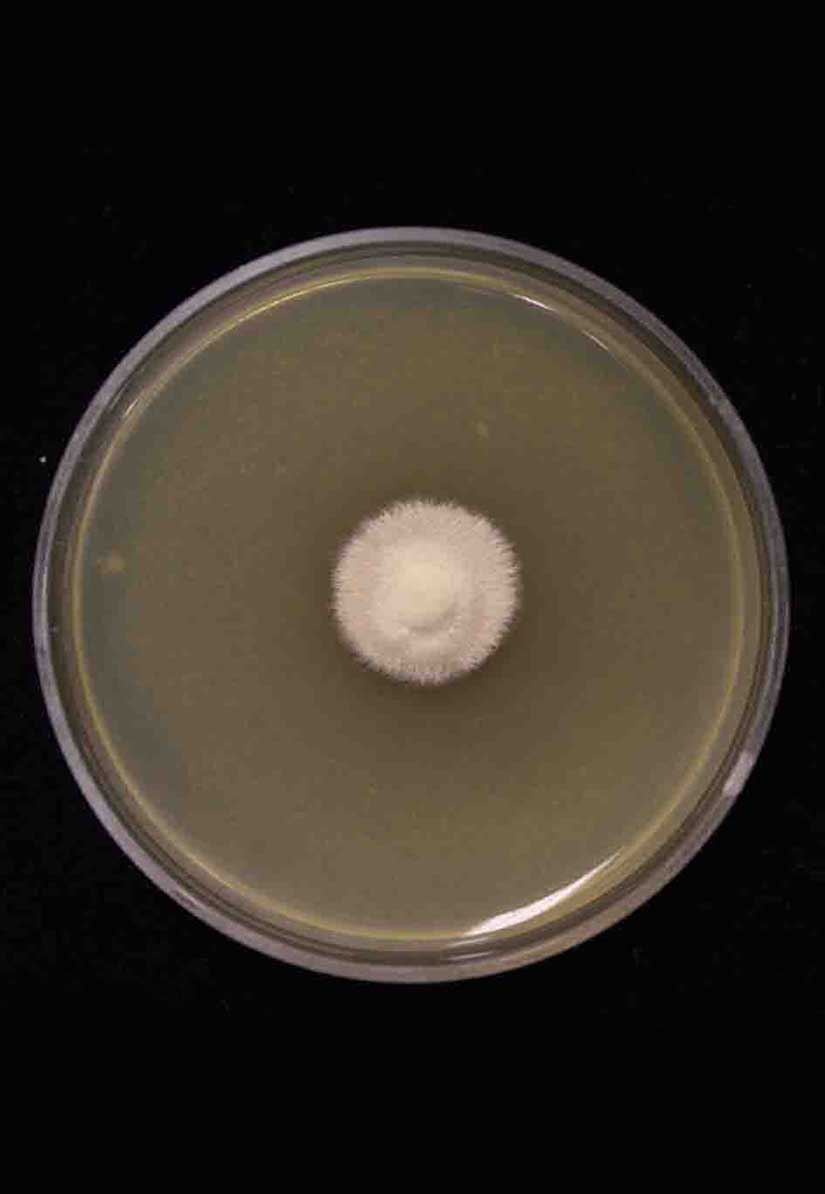

Holotype:
SRI LANKA, K98612 – holotype deposited in the Kew Gardens Fungarium.
Habitat:
Underside of leaves.
Host:
On Blattodea, Blattidae.
Description:

Stroma several, 6–13 mm long, 200–350 μm wide, cylindrical, pale pink. Fertile head was distinctly sub-terminal with the anamorph state at the apex. 
Perithecia immersed obliquely, ostioles projecting, elongate flask-shaped, 150–180 × 100–130 μm. 
Asci cylindrical, hyaline, capitate, 8-spored, up to 90 μm long, 6–8 μm wide, ascus cap rounded, 8–9 × 6–9 μm. 
Ascospores whole, cylindrical, 40–60 × 3–6 μm. Asexual morph: 
Conidiogenous cells polyblastic, cylindrical to clavate, 11–20 × 4.5–6 μm. 
Conidia ventricose, smooth walled, hyaline, 10–14 × 3.5–5.5 μm.
Culture characteristics:
Colony on PDA attaining a diam of 5 mm in 30 d, cream light brown, reverse brown. Colony on PDA did not produce any conidiogenous structures after 30 d.
Species |
Strain |
Compound |
Pubchem CID |
Biological activity |
Reference |
|---|
|
Strain |
- |
|---|---|
| BCC 34765 | - |
| BCC 38241 | MT512657 |